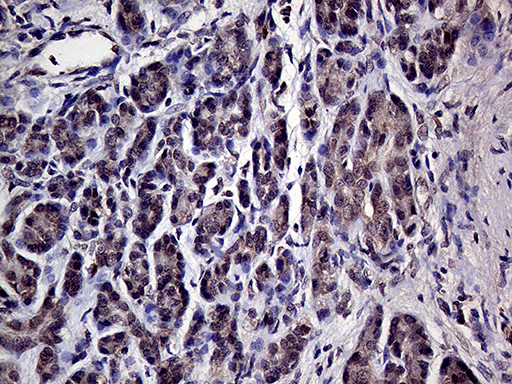
HABP2 Antibody in Immunohistochemistry (Paraffin) (IHC (P))

Search
OriGene
HABP2 Monoclonal Antibody (OTI5H3), TrueMAB™
{{$productOrderCtrl.translations['antibody.pdp.commerceCard.promotion.promotions']}}
{{$productOrderCtrl.translations['antibody.pdp.commerceCard.promotion.viewpromo']}}
{{$productOrderCtrl.translations['antibody.pdp.commerceCard.promotion.promocode']}}: {{promo.promoCode}} {{promo.promoTitle}} {{promo.promoDescription}}. {{$productOrderCtrl.translations['antibody.pdp.commerceCard.promotion.learnmore']}}
产品信息
TA809338
种属反应
宿主/亚型
分类
类型
克隆号
抗原
偶联物
形式
浓度
纯化类型
保存液
内含物
保存条件
运输条件
靶标信息
HABP2 is an extracellularserine protease that binds hyaluronic acid and is involved in celladhesion. The encoded protein is synthesized as a single chain, butthen undergoes an autoproteolytic event to form the functionalheterodimer. Further autoproteolysis leads to smaller, inactivepeptides. This protease is known to cleave urinary plasminogenactivator, coagulation factor VII, and the alpha and beta chains offibrinogen, but not prothrombin, plasminogen, or the gamma chain offibrinogen. Two transcript variants encoding different isoformshave been found for this gene.
仅用于科研。不用于诊断过程。未经明确授权不得转售。
篇参考文献 (0)
生物信息学
蛋白别名: Factor seven-activating protease; factor VII activating protein; Factor VII-activating protease; FSAP; Hepatocyte growth factor activator-like protein; Hyaluronan-binding protein 2; hyaluronic acid binding protein 2; plasma hyalurona; plasma hyaluronan binding protein; Plasma hyaluronan-binding protein
基因别名: FSAP; HABP; HABP2; HGFAL; NMTC5; PHBP
UniProt ID: (Human) Q14520
Entrez Gene ID: (Human) 3026